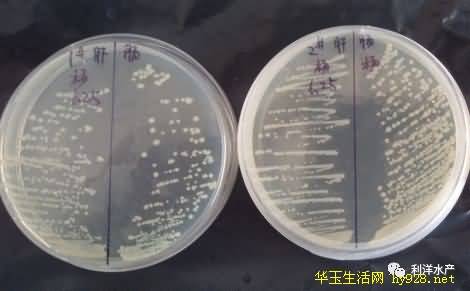

【技术交流】浅谈小龙虾的细菌病
小龙虾,原名克氏原螯虾,最早来源于美国,后经日本传入中国,目前已成为我国重要的淡水养殖经济品种。近几年小龙虾养殖如火如荼,但病害频发制约其产量的进一步增长。大多数人认为小龙虾没有疾病,因为他们在环境恶劣的臭水沟中都可以怡然自得。实际上并非如此,小龙虾养殖疾病发生率很高,特别是细菌病的种类多,危害也较大,下面就对小龙虾细菌病做简单介绍。

发病小龙虾
一、小龙虾细菌病的主要病原
据报道,目前能够感染小龙虾发病的细菌主要包括嗜水气单胞菌、副溶血弧菌和弗氏柠檬酸杆菌。嗜水气单胞菌与副溶血弧菌较为大家熟知,常出现在各类水产动物中,能够引起败血症等症状导致死亡,有时也能够感染人类导致腹泻等。弗氏柠檬酸杆菌,在普通培养基培养24h后,菌落表面光滑,边缘整齐,中间隆起,颜色偏白,直径1-2mm。革兰氏染色呈阴性,镜下呈短杆状,两端钝圆,药敏试验对恩诺沙星表现敏感。柠檬酸杆菌能够感染的养殖品种较多,在中华绒螯蟹、草鱼、鲫鱼、罗非鱼、锦鲤、鳗鱼、长吻鮠、鲟鱼、中华鳖、大鲵、棘腹蛙等中均有报道,能够引起其细菌性败血症并导致死亡。
生长24h左右的柠檬酸杆菌
二、小龙虾细菌病的症状
2.1 烂鳃
细菌感染破坏鳃组织,鳃丝逐渐发黄、发黑,影响呼吸系统正常运行,进而缺氧死亡。该病发生与水质好坏关系密切,水质恶劣时发病严重、影响较大。

黑鳃
2.2 烂尾
发病初期,尾扇边缘部分水肿,严重时可导致尾扇缺失、不完整。

尾扇肿胀

尾扇边缘溃烂
2.3 甲壳溃疡
常见于头胸甲,病灶初期呈微红色斑点,后逐渐变为黑褐色,严重时病灶中心凹陷中空,裸露内脏。

甲壳溃疡
2.4 心脏白浊
病变心脏呈现乳白色,无透明度,疑似与菌血症有关,心血淋巴液中可分离到致病菌。

心脏白浊
2.5 肝脏色浅或暗黄
正常小龙虾的肝脏颜色呈橘黄色,质地结实,病变后的肝脏呈浅黄或暗黄色,严重时呈糜烂状。

肝脏颜色浅黄

肝脏颜色暗黄
2.6 空肠
小龙虾肠道中的常在菌群多种多样,但当受到外界刺激后会发生变化,有害菌数量增多,引起肠道病变。

空肠
虽然小龙虾细菌病频发,症状多样,但由于缺乏对细菌感染的深入细致研究,目前无法通过症状来判断致病菌的种类。
三、小龙虾细菌病的防治
细菌病的多数病原菌均属于机会致病菌,当池塘环境恶化时才会使细菌大量繁殖,增强细菌的致病力,诱发疾病。而且细菌病发生时,有时并发白斑病毒病,尤其在4-6月份最为普遍,死亡率高。所以大家在处理时应谨慎从事,避免发病时因用药不当加重死亡。建议以预防为主:定期调水、改底,改善池塘环境,稳定水体;内服营养保健,增强体质,提高抗病能力;细菌病高发期使用生态消毒剂“优肽”(噬菌蛭弧菌),减少池塘病原菌数量,降低发病影响;注重增氧,勤开增氧机,保证池塘溶氧充足,缺氧是小龙虾发病的主要诱因之一。
